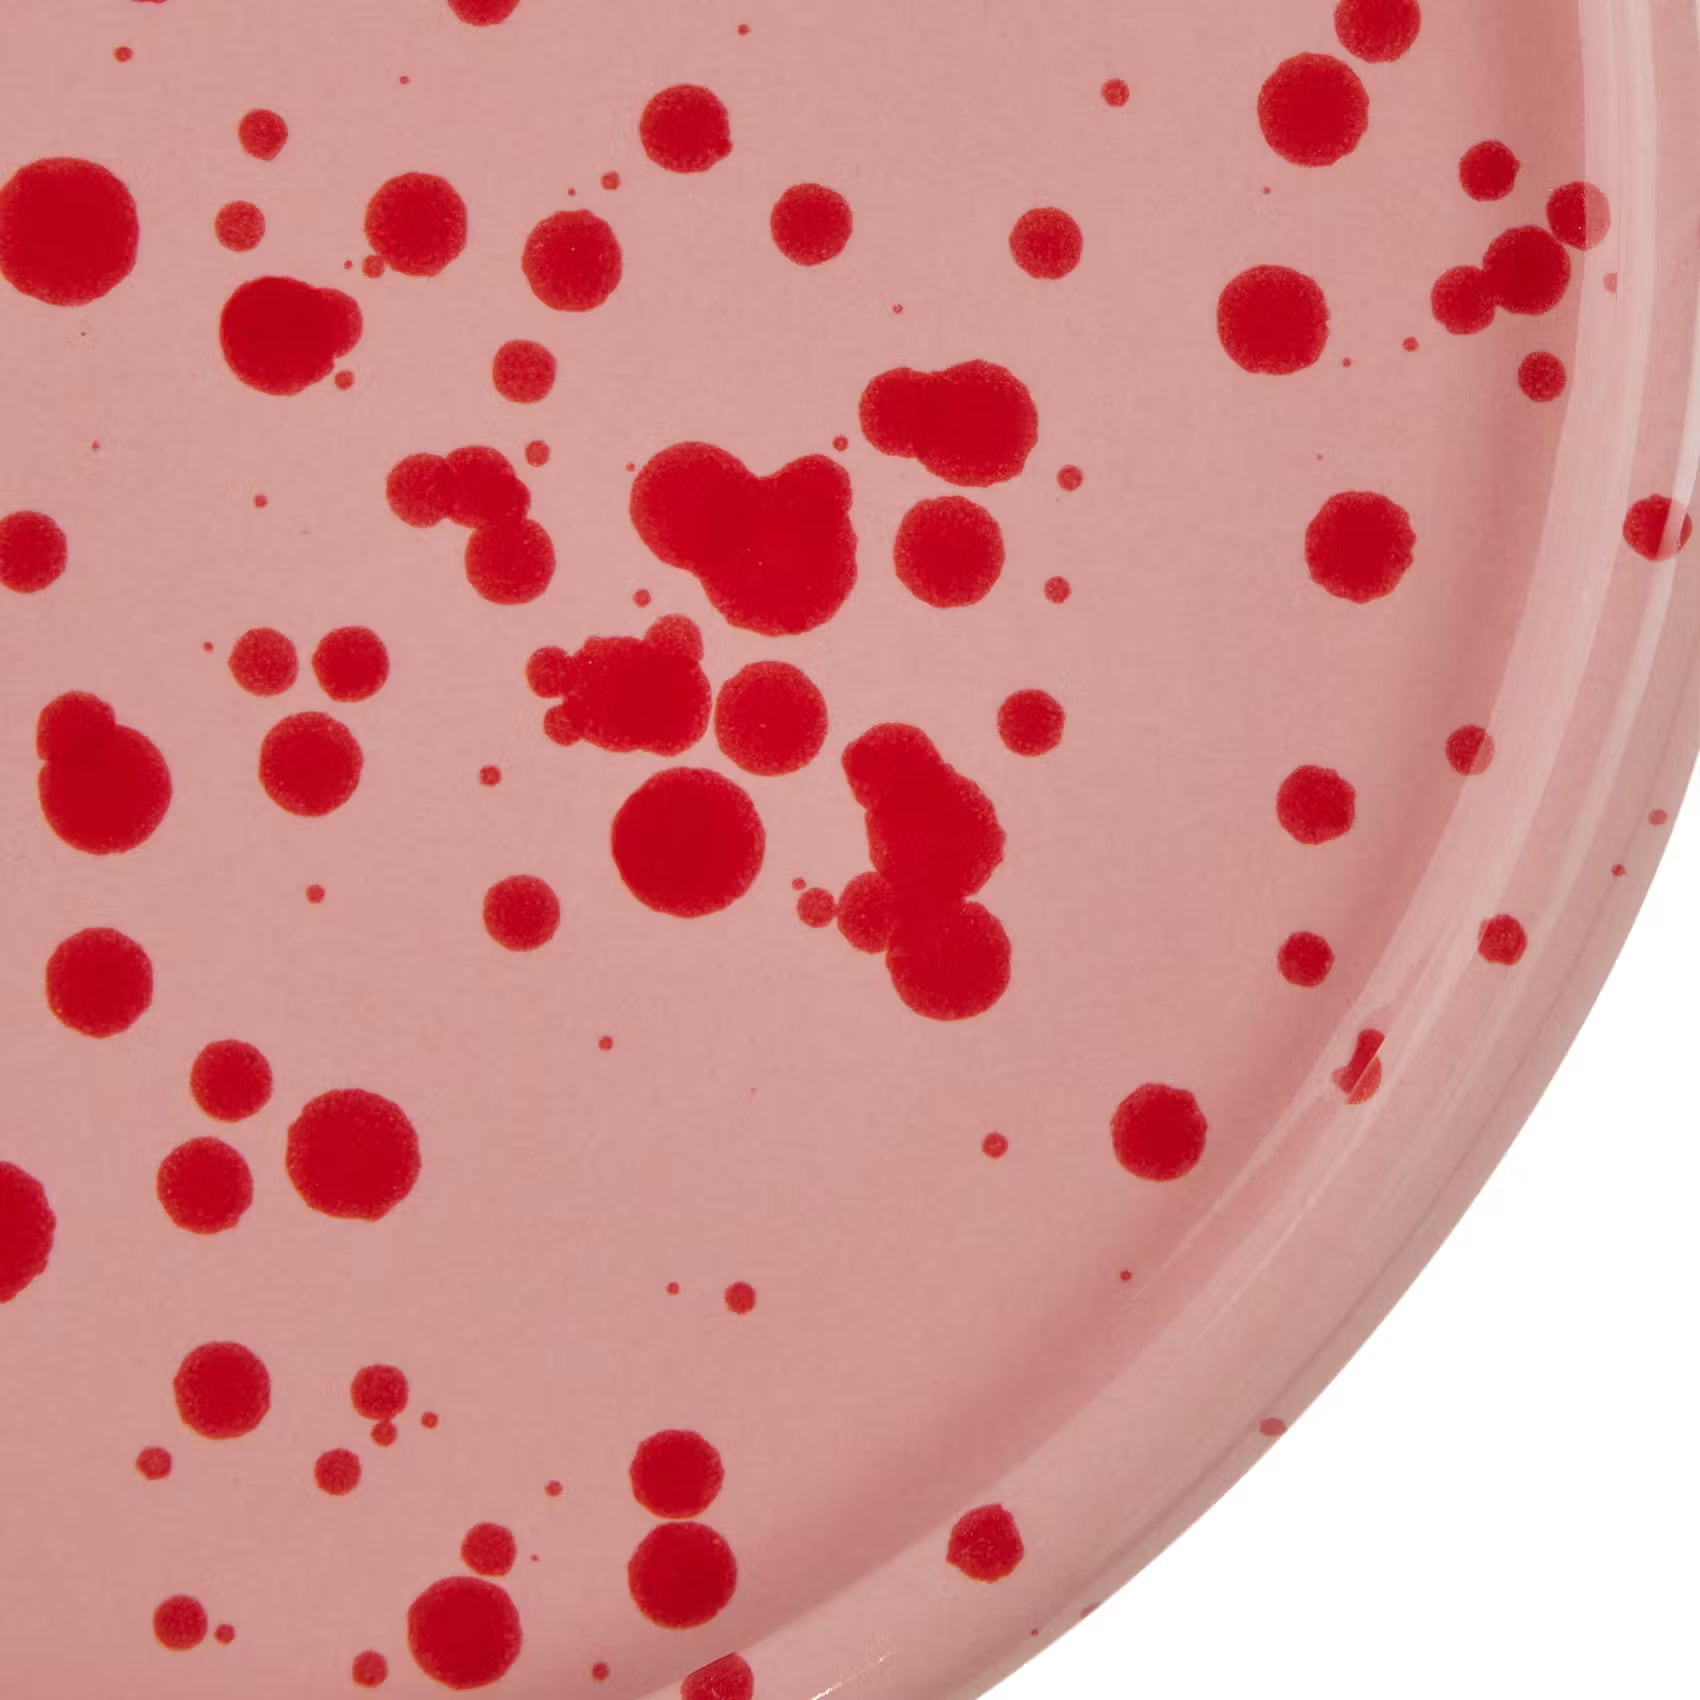

BOOGY SPLASH Frühstücksteller
BOOGY SPLASH Frühstücksteller
Stein - Violett
Auf Lager
-
Lieferung: ca. 27. Jun. - 30. Jun.
Artikeldetails
Artikeldetails
Beschreibung
Lebendige Tupfer tanzen auf dem Boogy Splash Frühstücksteller. Das minimalistische Geschirr aus hochwertigem Steinzeug ist organisch geformt und greift, ganz modern, die abgerundete Form eines Frisbees auf. Dieser besondere Look und die neutrale Farbwelt machen die Teller und Schalen der Boogy Splash Geschirrserie zu einem Statement Pieces auf dem gedeckten Tisch. Verschiedene Farben erhältlich, perfekt für dein individuelles Mix & Match.
Versand & Lieferung
Versand & Lieferung
| Versandart dieses Artikels: Paketservice |
Folgende Versandarten bieten wir zu den genannten Kosten an:
Paketservice
|
Warenwert |
Versandkosten |
|---|---|
|
ab € 0,00 |
€ 5,99 |
|
ab € 59,00 |
€ 2,99 |
|
ab € 89,00 |
kostenlos |
Paketservice - Sperrgut *
|
Warenwert |
Versandkosten |
|---|---|
|
ab € 0,00 |
€ 14,99 |
2-Mann-Handling / Möbelspedition
|
Warenwert |
Versandkosten |
|---|---|
|
ab € 0,00 |
€ 39,99 |
|
ab € 300,00 |
€ 59,99 |
Innerhalb einer Bestellung werden die Kosten für verschiedene Versandarten aufsummiert. Im Checkout wird dir angezeigt, ob der Kaufvorgang mehrere Versandarten umfasst. Zudem kannst du vorab im Warenkorb die Versandkosten kalkulieren lassen.
*Paketware mit einem der folgenden Kriterien gilt als Sperrgut:
Für Deutschland:
- Längste Seite: mehr als 120 cm
- Zweitlängste Seite: mehr als 60 cm
- Lieferung besteht aus mehreren Paketen
Für Österreich:
- Länge, Breite oder Höhe über 175 cm
- Paketgröße über 300 cm (Gurtmaß)
- Lieferung besteht aus mehreren Paketen
Artikel- und Sicherheitsinformationen
Artikel- und Sicherheitsinformationen
Sicherheitsinformationen |
|---|
|
Warnhinweise & Sicherheitsinformationen |
Herstellerinformationen |
|---|
|
Name: BUTLERS GmbH & Co. KG Adresse: Hohenzollernring 16-18 D-50672 Köln, Germany Elektronische Adresse: https://www.butlers.com/ |